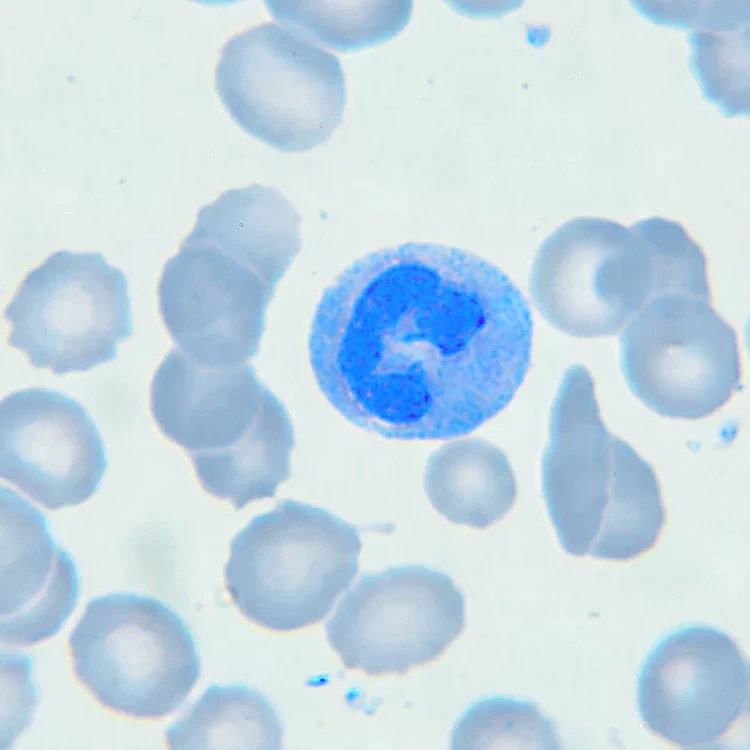

Определение стандартное разрешение 0.1mol/L 0.05mol/L 500 мл 1L ОКСАЛАТ натрия cas no 62 76 0 C2Na2O4 белый жидкий
- Категория: >>>
- Поставщик: Weifang Economic Development Zone Hot Point Biotechnology CenterWeifang Center
Сохранить в закладки 1600694842230:
Описание и отзывы
Характеристики
Hot-sale product
Products Description
Product Name | Sodium oxalate |
CAS | 62-76-0 |
Average Mass | 134 |
Appearance | Liquid |
Color | White |
Usage | Determination standard solution |
MOQ | 500ml |
Packing Specifications | 500ml/bottle, 1L/bottle |
Certificate | ISO/COA/MSDS/TDS |
Product packaging
Production process
Display of test results
Company Profile
Weifang Economic Hotspot Biotechnology Center, found In 2013,has since established itself as a strategic, reliable, and dominate link in the Organic synthesis and chemical supply chains.
Also experts in providing raw materials to the adhesives and sealants, paints and coatings, agricultural chemicals, excipients, and flavor and fragrance markets.
We partner with companies across the world to establish and maintain strong relationships that allow us to source the highest quality chemical products available.
Hotspot Biotechnology applies cutting-edge sourcing strategies to your supply chain as an extension of your business. we can provide you with the best possible solutions.



Why Choose Us

FAQ

Q1:Can I get some samples?
A: Of course.If you need samples, please contact us.
Q2: How is the Product Quality confirmed before placing orders?
A: First, we will send the sample for you to test as well as our COA /testing result.
Otherwise, we can work with a third-party inspection of your choice.
Q3: What's your MOQ?
A: Normally, our MOQ is 1kg. But it can be adjusted according to your requirements.
Q4: How about delivery time?
A: Orders are shipped within 3-5 working days after payment confirmation. (Chinese holiday are NOT included)
Q5: Can I get a discount?
A: Discounts are based on quantity where is available, contact us for current details.
Q6: How do you treat quality complaints?
A: First of all, our quality control ensures our quality is consistently high. If there is a real quality problem caused by us, we will replace inferior products for you or refund your loss.
Q2: How is the Product Quality confirmed before placing orders?
A: First, we will send the sample for you to test as well as our COA /testing result.
Otherwise, we can work with a third-party inspection of your choice.
Q3: What's your MOQ?
A: Normally, our MOQ is 1kg. But it can be adjusted according to your requirements.
Q4: How about delivery time?
A: Orders are shipped within 3-5 working days after payment confirmation. (Chinese holiday are NOT included)
Q5: Can I get a discount?
A: Discounts are based on quantity where is available, contact us for current details.
Q6: How do you treat quality complaints?
A: First of all, our quality control ensures our quality is consistently high. If there is a real quality problem caused by us, we will replace inferior products for you or refund your loss.
Title goes here.
Semi-Automatic PET Bottle Blowing Machine Bottle Making Machine Bottle Moulding Machine
PET Bottle Making Machine is suitable for producing PET plastic containers and bottles in all shapes.
PET Bottle Making Machine is suitable for producing PET plastic containers and bottles in all shapes.
Похожие товары
Натуральный фермент 5000 Бромелин порошок для ухода за кожей чистый
53,00-66,00 $
Hatmanlabs 10 в 1 смесь грибов Черный Кофейный порошок частная марка натуральный органический грибной кофе энергетический заряд растворимый
2,64-3,17 $
90% экстракт конжака Koniacmannan Konjac Glucomannan порошок
Заводская поставка 100% натуральная пила экстракт пальметто жирная кислота 25% ~ 45% сереноа репены порошок
Доступные высококачественные оптовые поставки чистых порошков Индиго подходящих для всех ваших потребностей в краске волос
3,00 $
Фабрика по лучшей цене сырое очищенное оптом органическое рисовое масло отрубей
3,00 $
Оптовая продажа капсулы омолаживающие альфа-кетоглутарат кальция Сыпучие добавки 1000 мг CA-AKG
3,33-3,88 $
Новые поступления
Новинки товаров от производителей по оптовым ценам
Светлая Золотая морская солнечная энергия ландшафтное украшение постмодерн минималистский стиль чистая ручная роспись маслом 24x3 1 дюйм/60x80
35-53 $
Европейские антикварные простой Последние двойной металлической кровати
Автоматизированная складская система автоматического хранения в Гуанчжоу Eyda с эффективными стеллажами и
10 000-35 000 $
Декоративный чехол для PS5 Сменный Чехол консоли пластины Playstation5 пылезащитный с защитой от царапин
7,50-7,70 $
Лучшее качество детские подгузники для сухих подгузников новорожденных размер 2 4 и большие доставка или
3 $
Выключатель для формованного корпуса Schneider NSX100N 50KA AC 3P3D 25A TMD новая модель C10N3TM025
Буф2-.. М .. Краны
Оптовая продажа высококачественный сублимированный клубничный порошок Заводская поставка
5,50-6,40 $